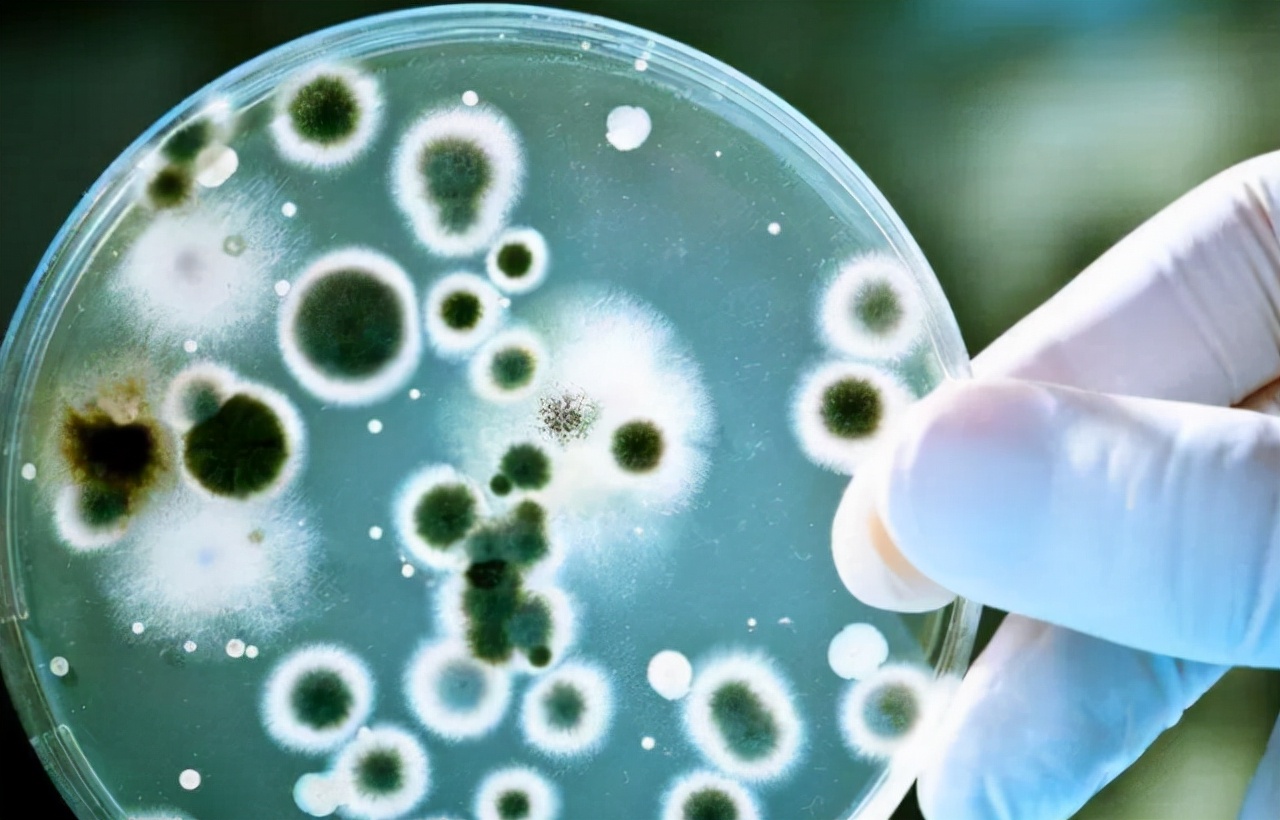
“阿莫西林”要了解，或对4种病有效，乱用、滥用或会引火烧身？

在这里要提醒大家,并不是所有的消炎药都是好药或者是坏药,消炎药也是要根据自身的真实情况,包括细菌感染的程度来积极选择,而且不同的消炎药,它们的抗菌效果是不同的,药物成分也不同。
广谱类的消炎药,包括青霉素以及头孢类抗生素 ,这主要是针对所有敏感菌导致体内出现炎症时,可以服用,能够起到很好的 抗菌 效果。
但是有一部分的消炎药, 只是用来针对特殊的菌群才有明显的缓解作用, 比如 甲硝唑,主要是用来治疗厌氧菌很有效, 所以我们在选择消炎药的时候,要根据具体的感染类型才可以对症下药。

大家常见的消炎药是哪一种呢? 应该是阿莫西林吧,相信大多数人对于他肯定很熟悉,但是大家真的了解他吗?
有一部分人感冒的时候会把阿莫西林感冒药放在一起使用, 使身体恢复得更快,但 也有人说这是抗生素的药物, 只有细菌感染的时候才能服用 ,到底哪一种说法才是正确的呢?阿莫西林可以用来治疗哪一些疾病?不妨一起来了解一下。
01
首先,我们先来看一下阿莫西林是什么?
不管是在临床医学中还是在日常生活当中,阿莫西林是应用范围比较广泛的抗生药物,它可以用来治疗半合成的青霉素抗生药物,它主要是分为胶囊、分散片以及片剂。
在医学的角度来讲,阿莫西林有被人称为羟氨苄青霉素,它是一种常用的口服青霉素,也属于抗生素的一种。其次阿莫西林还有普遍的抗菌活性,对于杆菌的抗菌活性比较有效。

由此可见,阿莫西林也是青霉素当中的一种抗生类药物,能够抑制体内细胞内壁的合成,起到杀菌消炎的效果,而且它的抗菌谱范围用途广,能够用来治疗革兰阳性的细菌,也包括革兰阴性的细菌。
另外,阿莫西林也可以用来治疗钩端螺旋体感染,由于敏感的细菌所引起的体内不适状况,或者是其他器官受到的多方面感染,都能够得到有效的缓解。
02
“阿莫西林”要了解,或对4种病有效,乱用、滥用或会引火烧身?
1、泌尿系统的感染
一般情况下,如果泌尿系统受到感染的话,可以服用阿莫西林片。

阿莫西林片可以用来治疗常见的泌尿系统出现的细菌感染,有起到明显的抗菌消炎的效果,同时服用阿莫西林肠溶片,能够治疗泌尿系统所出现的尿频,尿急,排尿疼痛等情况。
2、皮肤软组织受到感染
如果你发现皮肤软组织受到感染时,可以服用一些阿莫西林片,能够起到有效的抗菌消炎的效果,有效抑制体内感染范围。
它可以用来治疗溶血链球菌、葡萄球菌等其他细菌所导致的皮肤软组织感染情况,能够在最大程度上缩小感染的范围,缓解身体不适。
3、上呼吸道感染

在临床医学中,上呼吸道感染也是常见的一种疾病,它主要是因为感染了一些病原体之后,所导致的呼吸系统出现异常问题。
主要是受到病毒、衣原体、细菌、支原体等其他病菌所造成的咽喉部位发生感染,在这种情况下,患者也可能会出现咽喉疼痛、发烧等其他异常情况。
如果我们发生呼吸道感染时,医生一般会建议我们把抗病原体有效控制,如果考虑到患者的感染病原体为细菌,那么可以适当的服用一些阿莫西林片进行治疗。
首先应该找出上呼吸道感染是受到病毒性感染还是细菌性感染,根据具体情况具体分析,找出最有效的治疗方案,更有利于起到杀菌消炎的效果。
如果是患有炎症性感染的话,可以选择服用阿莫西林来起到消炎杀菌的效果,快速地恢复身体健康,缓解咽部疼痛的情况。
4、下呼吸道受到感染
如果呼吸道受到细菌的感染,可以考虑服用阿莫西林片,能够缓解急性的呼吸道感染、支气管炎、肺气肿、肺炎、支气管扩张综合征、或者是其他细菌感染等等。
由此可见,阿莫西林的用途比较广,是一种强有效的抗生素,能够很好地杀灭体内革兰氏细菌,对于身体当中的细菌感染能够起到有效的抑制作用。

但是也有一部分患者由于长期使用抗生素,呼吸道细菌会出现一些耐药性,这种情况下,建议大家可以选择阿莫西林克拉维酸钾制剂,能够对于体内的病毒起到有效杀菌的作用,防止身体出现耐药性。
03
如果长期服用阿莫西林会给身体带来哪些不良影响?
1、身体过敏
如果长期服用阿莫西林会导致身体出现一些过敏反应,比如皮肤发红、瘙痒难耐、丘疹、皮疹、药疹、*麻疹荨**等等,如果得不到及时的控制,有可能会导致患者出现哮喘反应。
2、影响肝脏以及肾脏功能

如果长期服用阿莫西林药物,可能会导致部分患者出现肝脏以及肾脏功能降低的现象,导致体内的转氨酶含量持续升高,增加肌酐以及尿素氮水平升高的风险。
3、神经中枢受到影响
也有可能会导致神经中枢受到影响,使患者经常出现偏头痛、失眠、入睡困难、异常兴奋、头晕眼花、焦虑不安的精神状态。
也有个别的患者身体素质比较差,会出现一些耐药性的细菌感染,比如念珠菌以及其他细菌感染自己的身体部位。
4、肠胃功能下降

是药三分毒,而且长期服用药物会给肠胃带来一些刺激,有可能会导致患者出现恶心、呕吐、胃酸、烧心、腹泻、肠胃疼痛等其他肠胃不适状况,如果情节严重者,也有可能会引起伪膜性肠胃炎。
5、血液系统异常
药物经过肠胃分解之后,会跟随我们的血液运输到各个器官,从而起到杀菌的效果,但是长期服用阿莫西林也会引起血液系统出现异常情况,比如会导致身体当中的红细胞减少,血小板数量随之降低,会增加嗜酸性粒细胞不断增多,影响血液健康。

综上所述,虽然阿莫西林的用途比较广,能够给身体带来一些有效的治疗,但是大家一定要根据具体情况来服用,以免给身体带来一些适得其反的作用,导致病情加重,不利于身体的恢复。
屏幕前的朋友们对于阿莫西林,你还有哪些其他的看法呢?可以在评论区分享出来,我们一起讨论看看。
#健康迎新年